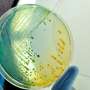

Dear Reader ,
Here is your customized Science X Newsletter for August 12, 2016:
Spotlight Stories Headlines
Astronomy & Space news
Scientists to unveil new Earth-like planet: reportScientists are preparing to unveil a new planet in our galactic neighbourhood which is "believed to be Earth-like" and orbits its star at a distance that could favour life, German weekly Der Spiegel reported Friday. | |
 | NASA's Fermi mission expands its search for dark matterDark matter, the mysterious substance that constitutes most of the material universe, remains as elusive as ever. Although experiments on the ground and in space have yet to find a trace of dark matter, the results are helping scientists rule out some of the many theoretical possibilities. Three studies published earlier this year, using six or more years of data from NASA's Fermi Gamma-ray Space Telescope, have broadened the mission's dark matter hunt using some novel approaches. |
 | Kepler watches stellar dancers in the Pleiades clusterLike cosmic ballet dancers, the stars of the Pleiades cluster are spinning. But these celestial dancers are all twirling at different speeds. Astronomers have long wondered what determines the rotation rates of these stars. |
Technology news
 | Setting robots in motion, quickly and efficientlyHow can a drone get from one place to another in a forest, without colliding with any trees? How can a robot pick up a bolt and insert it into a casing, without smashing into any of the other moving objects in a crowded factory? Our ability to find a solution to this problem – which is called motion planning – will be critical to creating a new generation of robots that, unlike the industrial robots of today, can act in a world that has not been meticulously pre-prepared for them. |
 | Dragonfly shows simulated flight potentialFuturistic dragonflies are flapping their wings in the Biomimetics Lab at the University of Auckland's Bioengineering Institute. |
 | Researchers develop a low-power always-on camera with gesture recognitionSmart devices that wake up with voice commands have gained popularity in recent years, and now researchers at Georgia Institute of Technology have taken it one step farther: an always-on camera. |
 | New computer programme replicates handwritingIn a world increasingly dominated by the QWERTY keyboard, UCL computer scientists have developed software which may spark the comeback of the handwritten word by analysing the handwriting of any individual and accurately replicating it. |
 | Ad blockers out-flank FacebookAd blockers on Thursday said they foiled a move by Facebook to sidestep software used to stop marketing messages at social network pages visited on desktop computers. |
 | Calling China: phones everywhere in world's biggest marketSometimes it seems that no one in China, from toddlers to octogenarians, ladies in swimming pools to delivery men mid-manoeuvre, is without a cellphone to hand—and statistically it is more or less true. |
 | False shutdown rumor fuels #SaveTwitter frenzyTweets regarding Twitter's pending demise are greatly exaggerated.Despite a rumor to the contrary, the global one-to-many messaging service on Thursday had no plans to shut down any time in the foreseeable future due to the bane of cyber bullying. |
 | NASA pulls together national data to sleuth out air traffic improvement mysteriesFor the first time ever, air traffic researchers can view and analyze archived flight data collected and merged from all air traffic facilities across the U.S., with fast update rates ranging from one second to 12 seconds for every flight's position. Previously, researchers only had access to national flight data that was similar to internet flight tracking, with one-minute flight updates and no information about flights on the ground at airports. Or, they had access to separate flight data sets from 77 different Federal Aviation Administration (FAA) air traffic facilities, which made research very challenging. NASA's newly improved tool, the Sherlock Air Traffic Management (ATM) Data Warehouse, merges all of the air traffic facility data to produce analysis-ready, end-to-end flight information at these improved resolutions for the entire U.S. airspace. |
 | Computer programming made easierNobody said computer programming was easy. But maybe in the future, it could be. |
 | Architecture students, faculty design floating cities in response to climate changeWhat happens when architects think about the world beyond its physical framework is the concept explored by a team of architecture students and a faculty member from The University of New Mexico School of Architecture & Planning. It earned them an honorable mention in Pamphlet Architecture 36 competition. |
 | Is every human voice and fingerprint really unique?Barclays, the UK bank, is to replace the password system on its phone banking service with personal voice recognition. "Unlike a password, each person's voice is as unique as a fingerprint," said Steven Cooper, Barclays' head of personal banking. Yet the reality is we have no idea whether either fingerprints or voices are unique at all. |
 | How Pokemon Go turned couch potatoes into fitness fanatics without them even realising itPokemon Go is taking the world by storm. Within days of its US release, its number of daily active users caught up with longstanding apps Twitter, Snapchat and Google Maps, and it became the biggest mobile game in US history. Since then, the game has been launched worldwide, creating a user base which spends more time playing Pokemon Go than the average Facebook user spends on site. |
 | A.I. could be a firefighter's 'Guardian Angel'Firefighters have only their wits and five senses to rely on inside a burning building. But research developed in part by NASA's Jet Propulsion Laboratory, Pasadena, California, may change that, introducing artificial intelligence (AI) that could collect data on temperatures, gases and other danger signals and guide a team of first responders safely through the flames. |
 | Developing the next generation of solar cellsThrough a $900,000 grant from the Advanced Research Projects Agency-Energy (ARPA-E), the George Washington University has joined a partnership to develop novel solar cells and create what has the potential to be the world's most efficient solar panel. |
Smiley faces at small company making popular emoji appsMobile apps that allow users to create their own emojis or share the stylized images of NBA star Stephen Curry and other celebrities are paying off for a small upstate New York company. | |
 | California may beef up electric vehicle mandateA California lawmaker told The Associated Press on Friday that she's introducing legislation to require that 15 percent of new vehicles be emission-free in less than a decade, a significant escalation in the state's efforts to speed the evolution of new car technology. |
 | Microsoft buys interactive game streaming startupMicrosoft said it is bolstering its Xbox arsenal with the purchase of a startup specializing in letting people join in the fun while watching live-streamed game play. |
Taiwan's Hon Hai gets Chinese green light for Sharp dealTaiwanese tech giant Hon Hai said antitrust authorities in China had approved its takeover of ailing Japanese electronics maker Sharp, clearing the last obstacle to the drawn-out deal. | |
 | Scientist blazes the way for 3-D printing in Middle EastMetal additive manufacturing service bureaus are located in many regions over the world, but the Middle East is not one of them. Dr. Alaa Elwany, assistant professor in the Department of Industrial and Systems Engineering at Texas A&M University, jumped at the opportunity of a lifetime to participate in founding the first metal 3-D printing service bureau in this region. |
South Korea to review toxins data disclosure processSouth Korea plans to review if there was any negligence in the government's handling of sick workers' inquiries about workplace toxins, after an Associated Press investigation found the government repeatedly withheld such information following requests from Samsung. | |
Medicine & Health news
 | Needles that hit the right markMore than 13 million pain-blocking epidural procedures are performed every year in the United States. Although epidurals are generally regarded as safe, there are complications in up to 10 percent of cases, in which the needles are inserted too far or placed in the wrong tissue. |
 | Exercise can tackle symptoms of schizophreniaAerobic exercise can significantly help people coping with the long-term mental health condition schizophrenia, according to a new study from University of Manchester researchers. |
 | Baby food for thoughtIf you want your baby to love broccoli, you better love it, too, because that tiny human is watching you to learn which foods are good and bad. That's one of the takeaways in a new paper by a UC Santa Barbara researcher who investigated the way infants reason in socially smart ways about food. |
 | Large human brain evolved as a result of "sizing each other up"Humans have evolved a disproportionately large brain as a result of sizing each other up in large cooperative social groups, researchers have proposed. |
Study of brain activity shows that food commercials influence children's food choicesFood advertising is a multi-billion dollar industry, with approximately $1.8 billion annually aimed at children and adolescents, who view between 1,000 and 2,000 ads per year. Some studies have shown that there is a relationship between receptivity to food commercials and the amount and type of food consumed. In a new study scheduled for publication in The Journal of Pediatrics, researchers studied the brain activity of children after watching food commercials and found that the commercials influence children's food choices and brain activity. | |
Correcting metabolic deficiencies may improve depression symptomsIdentifying and treating metabolic deficiencies in patients with treatment-resistant depression can improve symptoms and in some cases even lead to remission, according to new research from the University of Pittsburgh School of Medicine published online today in the American Journal of Psychiatry. | |
Simple, sensitive, and cost-effective assays for analyzing Fragile X-related disordersFragile X syndrome, the most common heritable cause of intellectual disability and a frequent cause of autism, is characterized by abnormalities of the FMR1 gene that are difficult to analyze. Preclinical studies of Fragile X and the Fragile X-related disorders are hampered by the lack of low-cost and sensitive yet simple methods. National Institutes of Health (NIH) researchers have now developed a set of assays that are robust, cheap enough for routine research use, and may be suitable for initial patient screening, according to a new report in The Journal of Molecular Diagnostics. | |
Virtual reality and treadmill training could help prevent falls in older adultsCombining virtual reality and treadmill training helps prevent falls in older adults better than treadmill training alone, according to a new randomised controlled trial published in The Lancet. The authors say that the intervention, which combines the physical and cognitive aspects of walking, could potentially be used in gyms, rehabilitation centres or nursing homes to improve safe walking and prevent falls in older adults or people with disorders which affect movement such as Parkinson's disease. | |
 | Motorized prosthetics improves lives of amputeesWhen asked about her chosen field, Deanna Gates, director of the Rehabilitation Biomechanics Laboratory at the University of Michigan, always joked that she wanted to make Luke Skywalker's hand. |
Research finds maternal death rate increasing in U.S.The number of women who die during or soon after pregnancy is on the rise in the United States, while on the decline internationally, according to new research from the University of Maryland Population Research Center (MPRC). | |
Two new drugs show promise for patients with aggressive breast cancerPatients with aggressive subtypes of locally-advanced breast cancer may have new treatment options on the horizon, according to two reports published in July in the New England Journal of Medicine. Results of two different investigational arms of a multi-drug phase II trial conducted in part by researchers at the Perelman School of Medicine at the University of Pennsylvania and the Abramson Cancer Center, show that use of new targeted therapies neratinib or a combination of veliparib and carboplatin improves outcomes, when used in addition to standard chemotherapy before surgery for patients with HER2-positive and triple-negative breast cancer, respectively. The results are part of the multi-institutional I-SPY 2 study. | |
World Breastfeeding Week: Conflicts of interest in infant and young child feedingIn the aftermath of World Breastfeeding Week, leading academics in infant nutrition from the Australian National University, Julie Smith, Libby Salmon and Phillip Baker, examine the challenges that remain in keeping breastfeeding on the global agenda. | |
 | What types of hydrogel fillers best promote functional recovery in nerve regeneration?Methods to improve nerve regeneration using nerve conduits filled with hydrogels can differ significantly in their ability to promote functional recovery depending on the porosity of the conduit and the bioactivity of the hydrogel, according to a new study published in Tissue Engineering, Part A. |
 | Research supports targeting enzyme group to treat autoimmune diseasesNew research from the University of Dundee, and funded by Arthritis Research UK and the MRC, has shown that targeting a specific group of enzymes could be a viable strategy for treating autoimmune diseases such as psoriasis and multiple sclerosis, which affect millions of people. |
Olympic Games shine a light on the 'cupping' techniqueWith the start of the 2016 Summer Olympic Games in Rio de Janeiro, the use of the ancient 'cupping' technique by various athletes, to supposedly improve their recovery time and allow for better performance, has been one of the most commented upon aspects of the Games thus far. However, scientists are divided over whether or not the technique has actual physical benefits beyond the creation of a placebo effect. | |
 | The psychology behind the tiny house movementTiny homes have recently taken the housing market by storm, appearing all over rural and urban America as an affordable and eco-conscious solution to an increasingly tight housing supply. Generally between 100 and 400 square feet, tiny homes come in all shapes and sizes: From small portable cabins on wheels to trailers to "micro-apartments" that have appeared in San Francisco and New York City. |
 | Gastrointestinal illnesses cost the Swiss health care sector up to EUR 45 million per yearIn Switzerland, between 300,000 and 700,000 patients per year visit a doctor due to acute diarrhoea. Until now, the financial burden on the Swiss health care system had been completely unclear. The study, recently published in the scientific journal Epidemiology & Infection, estimates the costs entailed until a patient is cured. |
Pioneering anti-clotting drug helps reduce long-term risk for heart attack victimsA pioneering anti-clotting drug will soon be used to further reduce the long-term risks for heart attack patients after being given the thumbs-up from the National Institute for Health and Care Excellence (NICE). | |
Investigators chart microbial ecology of gingivitis, periodontitisGingivitis, a common and mild form of gum disease can progress to periodontitis, a more serious infection that damages the soft tissue of the gums and sometimes even destroys the bone supporting the teeth. An international team of researchers and clinicians has charted the microbial ecology of the mouth at all stages of this progression, in nearly 1,000 women in Malawi. This work is laying a foundation of knowledge that could lead to better oral health. The research is published August 12 in Applied and Environmental Microbiology, a journal of the American Society for Microbiology. | |
 | Alitretinoin cuts chronic hand eczema severity(HealthDay)—Alitretinoin treatment aids in normalizing expression of barrier genes and proteins in patients with chronic hand eczema (CHE), according to a study published online Aug. 2 in the British Journal of Dermatology. |
 | About half of older ICU survivors have functional recovery(HealthDay)—About half of older intensive care unit (ICU) survivors have functional recovery within six months, with higher body mass index and functional self-efficacy associated with recovery, according to a study published in the Aug. 1 issue of the American Journal of Respiratory and Critical Care Medicine. |
 | Renal denervation ups insulin sensitivity in preclinical model(HealthDay)—Inhibiting the sympathetic nervous system (SNS) by renal denervation (RDN) improves insulin sensitivity (SI) in obese canines, according to a study published in the August issue of Diabetes. |
 | CA-125 strategy cuts death, readmission in heart failure(HealthDay)—For patients discharged with acute heart failure (AHF), antigen carbohydrate 125-guided therapy (CA125-strategy) is associated with a significant reduction in the risk of one-year death or readmission for AHF, according to a study published online Aug. 10 in JACC: Heart Failure. |
 | Stepwise program can reduce diabetes incidence(HealthDay)—A culturally-tailored stepwise diabetes prevention program can reduce incidence of diabetes among overweight/obese Asian Indian adults, according to a study published online Aug. 8 in Diabetes Care. |
 | Polyethylene glycol 3350 doesn't cut time to bowel movement(HealthDay)—For women undergoing urogynecologic surgery, addition of polyethylene glycol 3350 (PEG3350) to docusate sodium does not reduce the time to first bowel movement, according to a study published in the September issue of Obstetrics & Gynecology. |
 | Tx response no different for migalastat, placebo in fabry's(HealthDay)—For patients with Fabry's disease, the percentage of patients with response at six months does not differ for those treated with the oral pharmacologic chaperone migalastat or with placebo, according to a study published in the Aug. 11 issue of the New England Journal of Medicine. |
| Drug resistance up for Shigella clusters among MSM(HealthDay)—Men who have sex with men (MSM) have elevated risk for antimicrobial drug-resistant Shigella infection, according to a report published in the September issue of the U.S. Centers for Disease Control and Prevention's Emerging Infectious Diseases. |
Phone checklist can help detect changes in clinical status among home care recipientsA simple phone checklist can help detect telltale changes in the health status of people receiving nonmedical home care, according to the findings of a pilot study led by investigators at Harvard Medical School. | |
Study finds Hispanic men in California need more screening for colorectal cancerColorectal cancer incidence and mortality rates in California have decreased markedly for men and women in all major racial-ethnic groups since 1990, except for Hispanic men. | |
 | Discovery of a brain sugar switchResearchers at Technical University of Munich discovered that our brain actively takes sugar from the blood. Prior to this, researchers around the world had assumed that this was a purely passive process. An international team led by diabetes expert Matthias Tschöp reported in the journal 'Cell' that transportation of sugar into the brain is regulated by so-called glia cells that react to hormones such as insulin or leptin; previously it was thought that this was only possible for neurons. |
 | Intestinal flora effects drug responseIntestinal flora has multiple influences on human health, but researchers have revealed that it is also likely to have an effect on the body's response to drugs. Recent research from Kumamoto University in Japan strongly suggests that changes in the intestinal flora, caused by antibacterial and antibiotic drugs or individual differences between people, may have an effect on a person's response to drugs including side effects. The research focused on the changes in proteins due to the condition of intestinal flora that affect the response to drugs in the liver and kidneys. |
 | Italian carries Zika in sperm for record six monthsAn Italian man carried Zika in his sperm for six months after showing the first symptoms of the virus, twice as long as in any previously reported case, according to a new study. |
 | Researchers pinpoint key influenza-fighting immune triggerSt. Jude Children's Research Hospital immunologists have identified the protein trigger in the body's quick-reaction innate immune system that specifically recognizes the influenza virus in infected cells and triggers their death. |
Canada reports first Zika-linked birth defectCanada Friday confirmed its first case of a birth defect related to the mosquito-borne Zika virus. | |
 | Clues in Zika's genomeUniversity of Utah chemists have found that the Zika virus contains genetic structures similar to other viruses in the Flaviviridae family, and that these structures may serve as potential antiviral drug targets. |
Black and Hispanic children and youth rarely get help for mental health problemsBlack children and young adults are about half as likely as their white counterparts to get mental health care despite having similar rates of mental health problems, according to a study published today [Friday, Aug. 12] in the International Journal of Health Services. Hispanic youth also get only half as much mental health care as whites. | |
 | Incidence of most fatal type of stroke decreasing—thanks to a decrease in smoking?A new study indicates that Finland's national tobacco policies seem to be radically reducing the incidence of subarachnoid haemorrhage, the most fatal form of stroke. |
 | Medicaid estimate renews cost concerns over 'Obamacare'The cost of expanding Medicaid to millions more low-income people is increasing faster than expected, the government says, raising questions about a vital part of President Barack Obama's health care law. |
3rd new Legionnaires case confirmed at Illinois veteran homeState officials have confirmed a third new case of Legionnaires' disease at a western Illinois veterans' home since an outbreak there last year killed 12 people and sickened 54. | |
Nigeria to start emergency polio vaccinations: UNICEFNigeria is planning to roll out emergency polio vaccinations starting late August after reporting two new cases of the disease, UNICEF said Friday. | |
 | Having primary care physician may not be enough to reduce ED visits by vulnerable groupsHaving a regular family physician may not be enough to reduce Emergency Department visits among patients with disabilities, a small study published online today in the journal Canadian Family Physician suggests. |
Cholera kills 16 people in C. African Republic, 34 in CongoCentral African Republic's health minister says at least 16 people have died from cholera and there have been 66 recorded cases since the beginning of August. | |
 | Puerto Rico reports 10,690 Zika cases amid ongoing epidemicThe U.S. territory of Puerto Rico has reported 1,914 new Zika cases over the past week. |
Swim in unsanitary freshwater site in Florida leads to infectionA swim in an unsanitary body of freshwater on private property in Broward County has resulted in a resident's hospitalization for a deadly infection caused by a brain-eating amoeba, health officials announced this week. | |
Biology news
 | Random walk into captivityThe cell's internal skeleton undergoes constant restructuring. LMU physicists now show that its constituent proteins can be efficiently transported to their sites of action by diffusion – provided they can be arrested when they get there. |
 | Global crosstalk limits gene regulationScientists at the interface of biophysics, evolutionary biology and systems biology develop new framework to analyze effects of global crosstalk on gene regulation | interdisciplinary collaboration between three IST Austria research groups leads to publication in Nature Communications. |
 | Study establishes the first public collection of bacteria from the intestine of miceMouse models are extensively used in pharmaceutical and medical research, and it is known that the communities of microbes in their intestine can have a significant impact on the research output. However, there is still insufficient information available about many bacteria inhabiting the intestine of mice. For the first time, a collection of cultured bacterial strains provides comprehensive information on the mouse gut microbiota: Scientists at the Technical University of Munich were able to isolate, characterize, and archive a hundred strains, including 15 hitherto unknown taxa. |
Male and female cats respond differently to distressed kittensFemale domestic cats adjust their response to kitten calls depending on how urgent they sound, according to a study published in the open access journal BMC Evolutionary Biology. Independent of their own experience of raising kittens, female cats distinguish between kitten calls that convey different levels of urgency and react accordingly, researchers at Hannover Medical School and the University of Veterinary Medicine Hannover, Germany have found. Male cats do not adjust their response in similar ways. | |
Tanzanian rats with nose for trouble train to save livesThey have proven their worth in detecting landmines but Africa's giant pouched rats have a lesser-known but equally critical vocation - saving lives by speeding up tuberculosis detection. | |
The caddisfly and its amazing underwater tapePatina Mendez is a caddisfly expert, so it's no surprise that when KQED Science's Deep Look wanted to get up close and personal with a caddisfly, they asked Mendez for help. | |
Lions in west and central africa apparently uniqueLions in West and Central Africa form a unique group, only distantly related to lions in East and Southern Africa. Biologists at Leiden University confirm this in an article published in Scientific Reports. | |
 | Watching molecular machines at workWhen one cell divides into two - that is how all forms of life are propagated - the newly born daughter cells have to be equipped with everything they will need in their tiny lives. Most important of all is that they inherit a complete copy of the genetic information from their mother cell. If this is not the case because a wrong number of chromosomes – on which the genetic information is stored – gets passed on during cell division, the daughter cells will often not survive, or worse, contribute to the development of diseases such as cancer or conditions such as Down Syndrome. |
Historically robust natural ecosystems could collapse due to climate change and human activityGlobal change will strike the oldest and most complex ecosystems of the world hardest, regardless of their past stability. This alarming finding is reported in a JRC-led article published in Nature Communications today. | |
 | Missing for a century, Singapore-born manatees re-settle in CaribbeanTwo Singapore-born manatees which were flown halfway around the world this week under a programme to restore Caribbean populations of the endangered sea cows are settling in well in Guadeloupe, their carers said. |
 | Discovery of a unique subcellular structure determining the orientation of cell divisionCell division is a fundamental process of life, producing two cells from one single cell at each cell division. During animal development, a fertilized egg divides many times, increasing the number of cells, which are precisely organized within the animal's body. How many times a cell undergoes cell division and how the two daughter cells are positioned after the division can be critical for shaping the animal. Although the machinery essential for cell division is well characterized and evolutionarily conserved, it remains unknown in most animals how a cell division can become oriented relative to the animal's body axis. |
This email is a free service of Science X Network
You received this email because you subscribed to our list.
If you no longer want to receive this email use the link below to unsubscribe.
https://sciencex.com/profile/nwletter/
You are subscribed as jmabs1@gmail.com
No comments:
Post a Comment